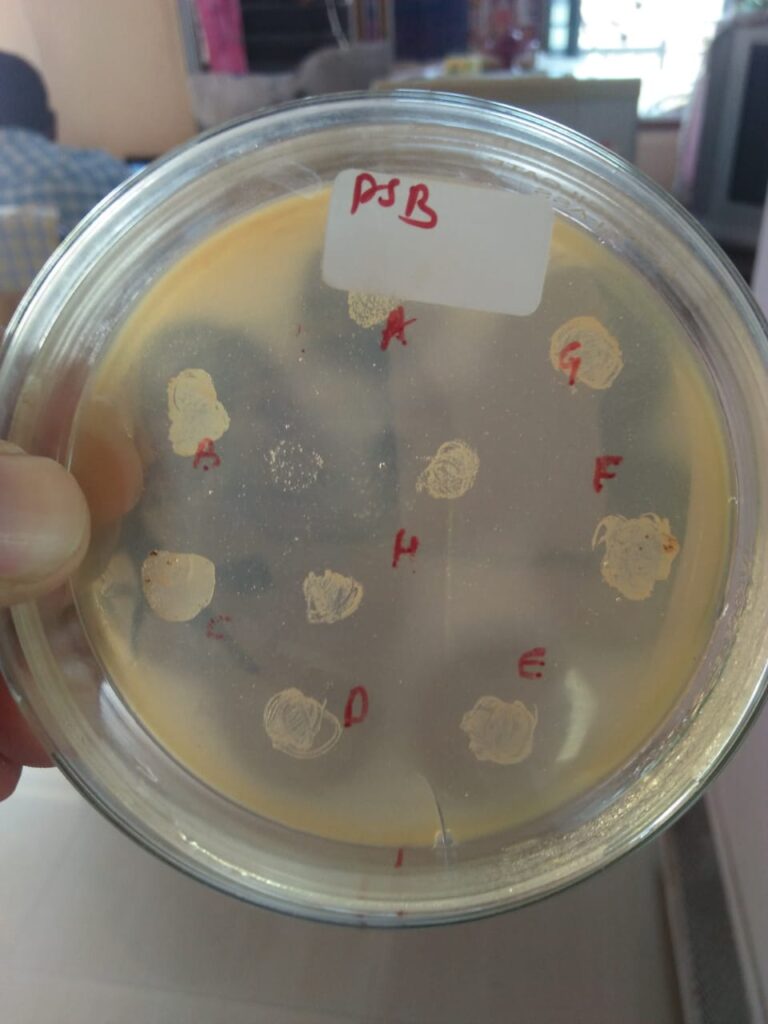

The reality of present-day agriculture is still undecided as to which way to go. One way is to completely depend on synthetic fertilizers and chemicals, which would mean the risks of soil degradation, environmental damage, and a decline in yield over the long term. The other way is a more balanced manner: making use of nature’s partners to restore soil, increase plant strength, and do crop production in a sustainable way. Biostimulants in agricultural practice and biofertilizers are the primary participants among these partners.
We will now look at what biostimulants and biofertilizers are, how they operate, their advantages, and the examples with data that will support our argument on why their adoption by farmers, researchers, and companies is a big step forward in shaping the future of agriculture.
The Urgent Need for Sustainable Agriculture
Decades of monoculture, intensive farming, and pesticides have finally gotten their revenge on it. Organic soil matter is being depleted, water tables are declining, runoffs of nutrients contaminate streams, and crops are becoming increasingly picky under stress from the climate. The United Nations conservatively estimates that almost a third of all soil on earth is degraded. With its current trajectory, a growing population becomes increasingly difficult to feed.
That is why sustainable agriculture is no longer a slogan, but a reality. Sustainable agriculture tries to satisfy food demands today in a manner that protects the environment safely, does not compromise the soil’s integrity, and guarantees future crops. It supports activity that recycles nutrients, maintains diversity, and minimizes dependency on outside chemicals.
To get to that point, however, measures need to jump the “less bad” horizon and set their sights on “actively regenerative.” That’s where biostimulants in agriculture and biofertilizers come in, not so much as an alternative fertilizer in itself (at least not yet), but as powerful catalysts that ignite plant virility, microbially healthy soil, and input efficiency.
What are Biostimulants in Agriculture and Biofertilizers?
Biostimulants are biological or natural products that enhance plant growth, tolerance to stress, and nutrient use efficiency. They act indirectly, not through the provision of nutrients but through activation of a plant’s internal process. They are amino acids, humic acid, and seaweed extract.
Biofertilizers are living organisms like Rhizobium, Mycorrhiza, or Azospirillum that fix atmospheric nitrogen, solubilize phosphorus, and improve soil health.
They fly together to be the twin pillars of agri biostimulants that assist farmers in slowing down the application of chemicals and evolving sustainable agricultural systems that are productive and balanced.
Since nature conflicts with chemical inputs, these organic stimulants are in harmony with nature, enhancing the quality of soil, water holding capacity, and crop quality.
How Biostimulants in Agriculture Work?
The science behind it is the secret to every thriving industry. That is what biostimulants do magic with in farming:
Improved Nutrient Absorption
Biostimulants manage root morphology so that plants are able to absorb nutrients in the optimal manner possible from subsoil layers. Humic acids and seaweed extracts, for instance, enhance nutrient uptake and minimize leaching loss, which is a real concern in green farming.
Stress Resistance
Drought, heat, or salinity – whatever stress, farm biostimulants enhance the defense mechanism in plants. Biostimulants in agriculture enable plants to generate defense enzymes and osmolytes so that plants can develop continuously under stress.
Boosted Microbial Activity
Biofertilizers promote beneficial microbes, which rejuvenate the fertility of soil and are therefore highly worthy of being good friends of sustainable farming.
Measures Yield and Quality
Scientific research shows that agricultural biostimulants can significantly boost crop productivity while improving overall quality, enhancing attributes like taste, texture, and nutritional value.
Each one of them doesn’t affect anything on its own, but collectively they allow agroecosystems to be productive and sustainable.
Why Biostimulants in Agriculture Matter to Farmers and the World?
For the farmer, the use of agricultural biostimulants is not about green credentials but profitability, predictability, and resilience.
Increased yield & input savings
Farmers are entitled to increased yield with reduced synthetic inputs. For instance, biofertilizers have been found to increase yields by 10–40 % and make it feasible to reduce the application of chemical fertilizers.
Soil fertility and health
Biofertilizers enable the recycling of soil organic matter, structure, and good microbial diversity. The soil is rendered more resistant to erosion and loss of nutrients over time.
Sustainability
Reduced utilization of synthetic fertilizers, for example, practices decrease greenhouse gas emissions (e.g., N₂O), loss of nutrients to leaching, and chemical contamination. Moreover, because biofertilizers can be produced locally with minimal energy (compared to industrial fertilizer production), they are a low-carbon technology.
Economic resilience
Low-cost technology and high productivity on smallholder farms enhance economic resilience. Farmers make fewer external, high-cost inputs in the long term.
Climate adaptation
In climatic uncertainty situations, crops, application of biostimulants perform better under heat or drought stress, sustaining productivity when the conventional system fails.
That is just one tale; sustainability is not a trend, it is the future.
Types of Biostimulants and Biofertilizers
There are two general groups of agricultural biostimulants that have diverse roles in sustainable agriculture:
Microbial Biostimulants & Biofertilizers
They are native microorganisms that increase soil nutrients and fertility levels.
They include:
- Nitrogen-fixing bacteria (CRhizobium, Azotobacter) for the conversion of nitrogen from the air to forms edible by plants.
- Phosphate-solubilizing bacteria liberate trapped nutrients in the soil.
- Mycorrhizal fungi can enhance root elongation for greater uptake of nutrients and water.
They are living things facilitating biostimulants in agriculture, restoring soil balance, and creating sustainable agriculture anew.
Non-Microbial Biostimulants
They are spontaneous, natural plant substances occurring naturally in the environment that stimulate natural plant metabolic and developmental processes.
Examples include:
- Seaweed extracts to induce stress tolerance and photosynthesis.
- Amino acids to stimulate plant recovery.
- Humic and fulvic acids improve soil structure and root growth.
All non-microbial and microbial biostimulant mixtures utilized by agriculture produce high-level synergy and form the biology of sustainable agriculture.
Practical Tips for Farmers Using Biostimulants
Greening up with farm biostimulants is not a question of getting rid of what works, but enhancing it. This is how to start incorporating them in your sustainable agriculture plan:
- Start Little by Little: Pilot a small plot to see how the crop reacts.
- Mix Correctly: Implement biostimulants in agriculture with fertilizers initially, and then discontinue chemicals slowly, little by little.
- Apply at Optimum Time: Initial growth phases, flowering, or stress phases prior to stress yield optimal results.
- Quality Inspection on Product: Check assured microbial content and approved formula.
- Verify & Compare: Track yield, quality, and soil parameters year by year.
Keep in mind, sustainable agriculture is not achieved in one time. For this, we have to build from season to season on healthy soil and smart practice.

Future of Biostimulants in Agriculture
With every new genomics, data computing, and AI soil mapping, the biostimulants in agriculture will be hyper-personalized for every climate and every soil. They will be paired with precision irrigation, drones, and smart sensors to make sustainable agriculture even better than ever before.
International policies such as the EU Green Deal and Mission LiFE (Lifestyle for Environment) of India also support natural inputs, and therefore, agri-biostimulants are policy-driven sustainability.
As per Fortune Business Insights (2025), the global agri-biostimulants market is expected to surpass USD 9.75 billion by 2032 due to growing demand for sustainable agriculture.
The Big Picture: Why This Movement Matters
Each handful of good soil contains billions of living organisms upon which the earth’s unseen builders depend. By activating that biology through biostimulants in agriculture, we’re not merely cultivating more plants; we’re cultivating ecosystems.
Sustainable agriculture is the coming together of productivity and stewardship in which growth never comes at the cost of the planet. And biostimulants in agriculture provide us with the means to achieve that balance on target.
As an agronomist, policymaker, or farmer, what is certain is that the future of agriculture lies in those who know biology as well as technology.
Invade Agro Philosophy: Leadership by Innovation
The fundamental belief at Invade Agro Global is that an intelligent, eco-friendly, and soil-conscious approach should be the three pillars of the farming future.
Besides, our R&D units have been engaged in a major push for the use in crop production through their eco-friendly formulations, microbial consortia, and educational programs for the farmers. Invade Agro’s provision of inexpensive bioinputs makes it easier for the farmers to transform their traditional farms into sustainable agriculture.
From India to East Africa, we prove that modern technology and ancient wisdom can go hand in hand to the extent that the outcome of the farming will be a mix of profit, ethics, and regeneration.